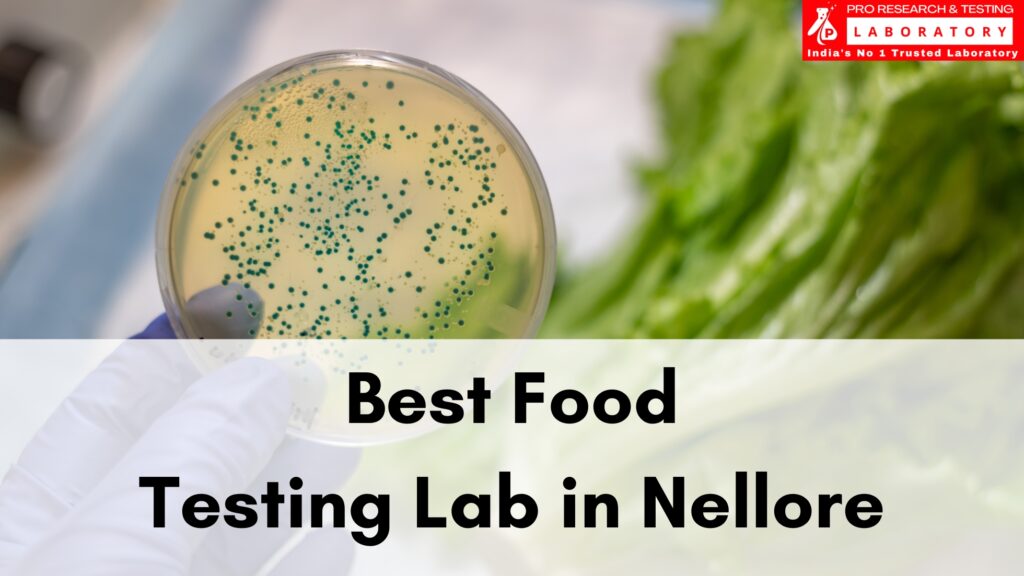
Best Food Testing Lab in Nellore to Protect Your Health Always

Know the Benefits of Drinking Water Testing Lab in Kolkata – Pro Research and Testing Laboratory
Kolkata has access to one of the most sacred rivers of India, the Ganga. But, over decades of neglect from both the government and common people, today we cannot claim that our drinking water is 100% safe for consumption. We know Kolkata does have enough water processing plants, yet, even now, the water supply we […]